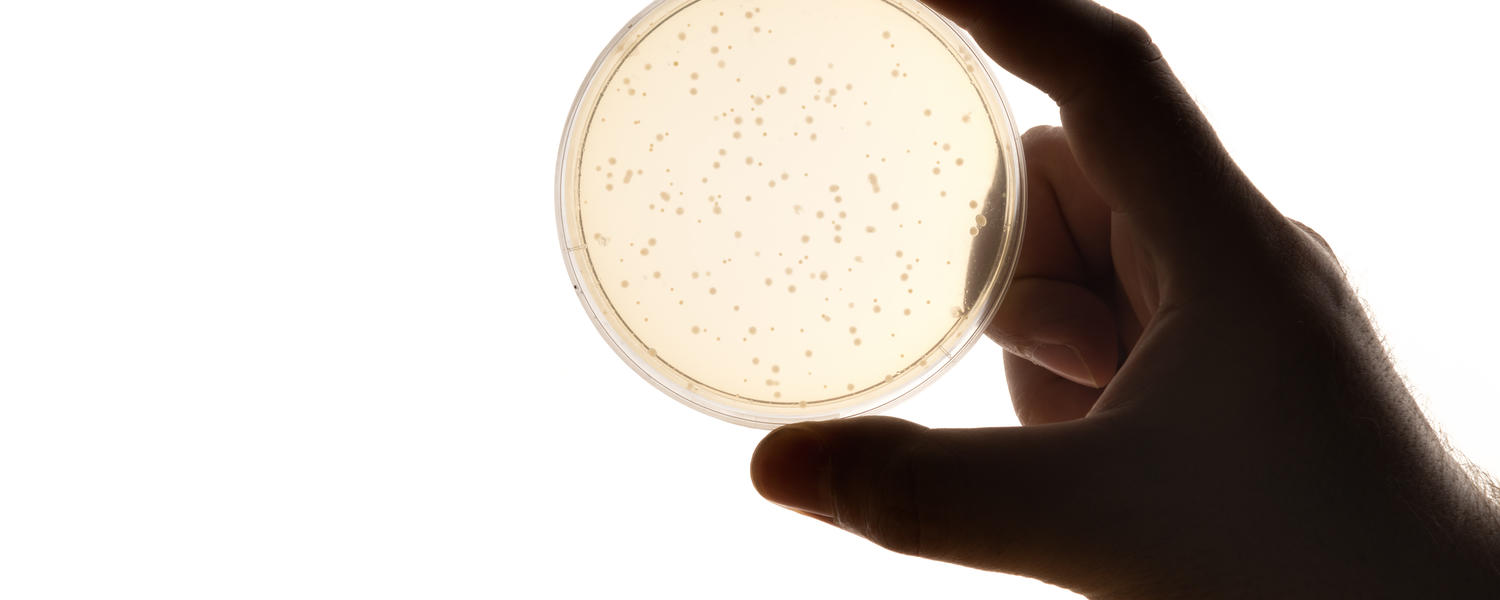
mdpa

Required Courses
WHMIS and Safety for Laboratories Training
Mandatory for university employees, graduate students and post-doctoral fellows working in a laboratory setting.
WHMIS (Non-Laboratory) Training
Mandatory for university employees and students working in a non-laboratory setting, with or near controlled products as defined by WHMIS legislation.
Radioactive Material Safety Training
Mandatory for university employees and students working with radioisotopes for research and/or teaching purposes.
Biosafety (Introduction) Training
Mandatory for university employees, graduate students, and post-doctoral fellows working with biohazards (Risk Group 2 or greater) for research or teaching purposes. Biohazards are pathogenic microorganisms, potentially infectious materials, as well as microbial toxins.